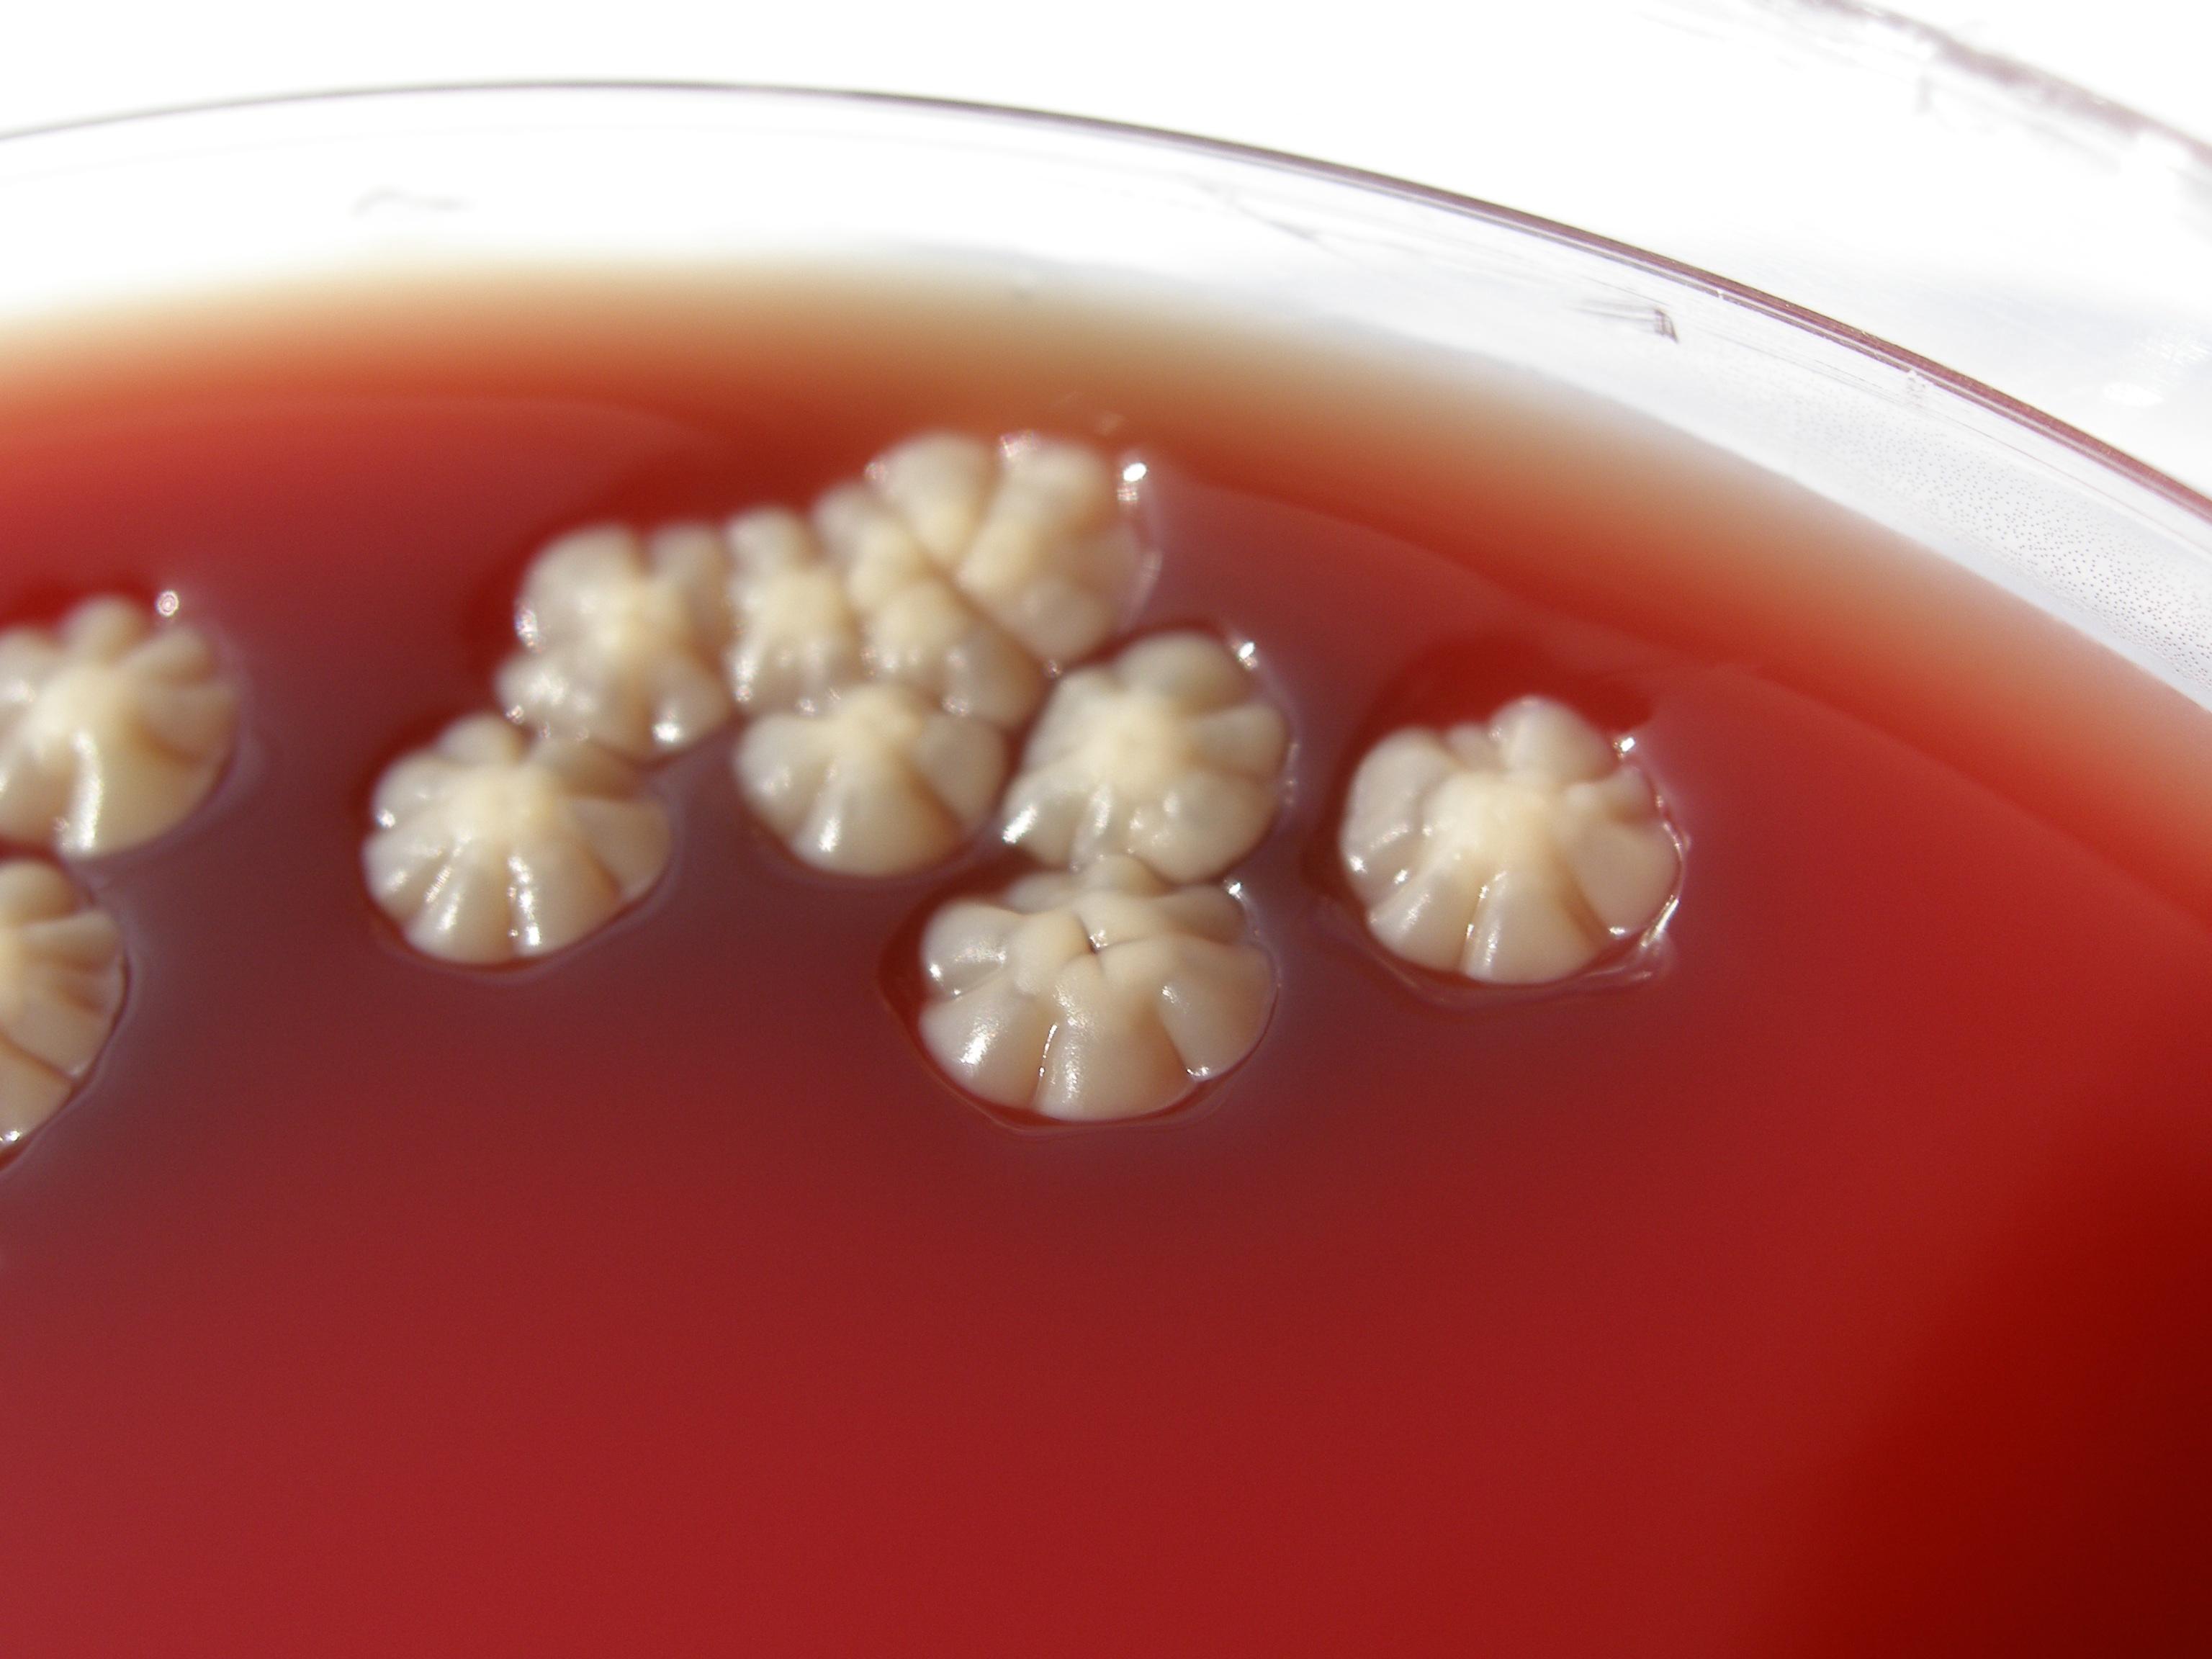
【转贴】奴卡菌照片

奴卡菌图片

【转贴】奴卡菌照片
图片尺寸3072x2304
【转贴】奴卡菌照片
图片尺寸3072x2304
出新隐和奴卡 写美篇淄博市第一医院陈群分离(下图),豚鼠耳炎奴卡菌
图片尺寸2667x2000
【转贴】奴卡菌照片
图片尺寸3072x2304
【转贴】奴卡菌 - hampc168 - hampc168
图片尺寸750x562
如何诊治继发性肺结核合并肺奴卡菌病
图片尺寸2756x974
帖子主题:奴卡菌病
图片尺寸640x480
【转贴】奴卡菌 - hampc168 - hampc168
图片尺寸750x562
咳嗽发热久治不愈,竟是养花引起的细菌感染
图片尺寸448x597
局限实变奴卡菌(转载)
图片尺寸748x500
肺奴卡菌病的临床与影像
图片尺寸960x720
拯救温夫人奴卡菌肺炎一例诊治分享
图片尺寸444x326
奴卡菌
图片尺寸561x386
我院检验科微生物室检出一例奴卡菌为患者带来福音
图片尺寸721x649
出新隐和奴卡 写美篇淄博市第一医院陈群分离(下图),豚鼠耳炎奴卡菌
图片尺寸869x854
刚出院又入院,反复咳嗽,发热,竟与种花养草饲鸽子有关
图片尺寸750x562
奴卡菌图片
图片尺寸450x300
少见的诺卡菌
图片尺寸1045x1000
肺奴卡菌病的临床与影像
图片尺寸960x720
奴卡菌的培养与鉴定
图片尺寸800x600